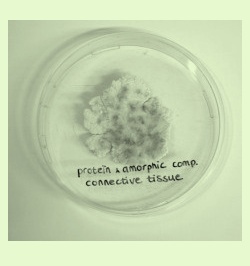

79.
PROTEIN & AMORPHIC CONNECTIVE TISSUE
PROTEIN & AMORPHIC CONNECTIVE TISSUE
Source: Product sample by Amber Veel.
See GLOSSARY:
AMINO ACID, ANATOMY, ASSEMBLAGE, ATTEMPT, BIOLOGY, BREAKDOWN PRODUCT, CRUST, DENATURE, LABORATORY, SHELL, STRATUM, SURFACE, TANNING, TISSUE
See WORK:
XVIII
AMINO ACID, ANATOMY, ASSEMBLAGE, ATTEMPT, BIOLOGY, BREAKDOWN PRODUCT, CRUST, DENATURE, LABORATORY, SHELL, STRATUM, SURFACE, TANNING, TISSUE
See WORK:
XVIII